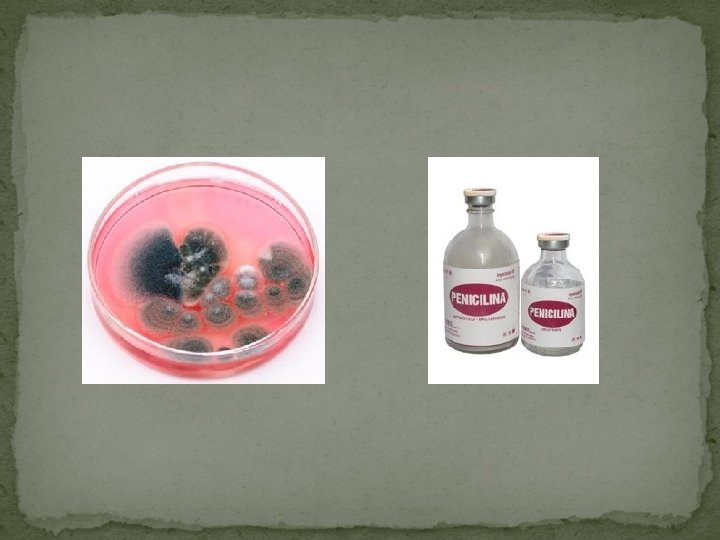

Tema 1 La medida El mtodo cientfico 1

- Slides: 34
Tema 1 La medida. El método científico.
1. - Las ciencias de la naturaleza La Ciencia es un conjunto de conocimientos sobre el mundo obtenidos a través de la observación, experimentación y razonamiento.
La Física es la rama de la Ciencia que estudia los cambios que se producen en la forma o estado de una sustancia pero sin modificar su naturaleza o características. Este tipo de cambios se denominan fenómenos físicos.
Ejemplo: los cambios de estado (como el que se produce cuando se derrite un cubito de hielo).
La Química es la trama de la ciencia que estudia los cambios que se producen en la materia que cambian la naturaleza de la misma. Este tipo de cambios se llaman fenómenos químicos.
Ejemplos: la combustión (que es quemar algo) es un proceso que estudia la Química, al igual que la oxidación de los metales.
También son fenómenos químicos algunos procesos que tienen lugar en los seres vivos como la fotosíntesis o la digestión.
No confundir la ciencia con las ciencias ocultas o pseudociencias, que son los conocimientos que se basan en la creencia o supersticiones, pero que a diferencia de los conocimientos científicos, no se pueden demostrar experimentalmente. Ejemplos de pseudociencia: la astrología (los horóscopos).
El tarot, que es la utilización de las cartas para interpretar el futuro. La homeopatía, que es un tipo de medicina alternativa iniciado a finales del siglo XVIII por un médico sajón en la que se utilizan sustancias naturales en lugar de químicas en el tratamiento de las enfermedades.
2. - El método científico Es el método de trabajo que siguen los científicos para adquirir nuevos conocimientos. Este método consta de varias etapas: 2. 1. - Observación de un fenómeno Consiste en examinar un fenómeno y plantearse preguntas sobre el mismo.
2. 2. - Formulación de hipótesis Consiste en buscar posibles respuestas a las preguntas planteadas durante la observación. 2. 3. - Experimentación Este paso consiste en realizar experimentos con idea de averiguar cuáles de las hipótesis son ciertas.
2. 3. - Extracción de conclusiones Consiste en analizar la información o los datos obtenidos en los experimentos para elegir las hipótesis verdaderas. Actualmente los ordenadores y los programas informáticos facilitan este paso.
Es el momento de elaborar una ley, que es una descripción detallada del fenómeno que se está estudiando. Un conjunto de leyes forman una teoría. Ejemplos: las leyes de Mendel o la teoría de la relatividad.
Ejemplo de trabajo científico: descubrimiento de la penicilina. La penicilina es un antibiótico empleado en el tratamiento de infecciones provocadas por bacterias.
Fue el primer antibiótico empleado en medicina y su descubrimiento es atribuido a Alexander Flemming, que junto con otros científicos médicos obtuvieron el premio Nobel de medicina en 1945 gracias al importantísimo aporte que significó para la medicina.
3. - Las magnitudes físicas y su medida Una magnitud física es cualquier propiedad o característica de la materia que se puede medir; es decir, a la que se le puede asignar un número y una unidad.
Ejemplos: masa, longitud, temperatura. . . Medir una magnitud consiste en compararla con un patrón que hayamos elegido al que llamaremos unidad para ver cuántas veces lo contiene.
3. 1. - El sistema internacional de unidades Aunque para medir una magnitud cada persona puede elegir el patrón que quiera, no es aconsejable, ya que algunos patrones nos pueden proporcionar medidas muy diferentes. Así si medimos por ejemplo el largo de la mesa utilizando como patrón la palma de la mano, probablemente nos salga una medida diferente a la de nuestros compañeros porque nuestras manos no son igual de grandes.
Por este motivo en 1960 los científicos decidieron en París qué patrones se utilizarían a nivel internacional y las magnitudes que se podían medir directamente con esos patrones. Así surgió el sistema internacional de unidades.
A las magnitudes que se definen por sí mismas se les denomina magnitudes fundamentales y son las siete que determinan el Sistema Internacional: Se llaman magnitudes derivadas a las que se obtienen a partir de las fundamentales haciendo operaciones con ellas o con otras derivadas.
Algunas magnitudes derivadas son:
3. 2. - Normas para escribir las unidades Cada unidad se representa por un símbolo formado por una o varias letras. Los símbolos se escriben con minúscula excepto cuando proceda de un nombre propio, en cuyo caso la primera letra se escribirá en mayúscula.
A los símbolos, aunque estén en plural, nunca se les escribe la “s” final. Ejemplo: 10 gramos se escribirá 10 g. Los símbolos se escriben sin punto final salvo que estén al final de una frase.
4. - Notación científica y cambio de unidades 4. 1. - Notación científica A veces trabajar con las unidades del sistema internacional supone hacerlo con números muy grandes o muy pequeños que tienen muchas cifras.
Así, para que resulte más cómodo trabajar con dichos números, se escriben con menos cifras utilizando una notación llamada notación científica. La notación científica consiste en escribir un número con una cifra entera seguida o no de decimales multiplicado por una potencia de diez.
Ejemplos: 26, 115 = 2, 6115 x 10 0, 000003 = 3 x 10 -6 -4 0, 000974 = 9, 74 x 10 -3 0, 00267 = 2, 67 x 10 7564, 39 = 7, 56439 x 10 3 8 149600000= 1, 496 x 10
4. 2. - Cambio de unidades Hasta ahora, para hacer cambios de unidades hemos estado utilizando la siguiente “escalera: Sin embargo esta escalera no nos permite hacer cambios de unidades en las que aparecen a su vez varias unidades. Para estos casos se recurre a un método llamado factor de conversión.
El factor de conversión consiste en multiplicar la cantidad queremos cambiar de unidad por una serie de fracciones que hay que determinar convenientemente. Ejemplo: pasar 72 km/h a m/s
Ejemplo: pasar 360 m/min a km/h 5. - El proceso de medir 5. 1. - Instrumentos de medida Los aparatos de medida juegan un papel fundamental en el método científico, pues durante la experimentación se utilizan mucho, de ahí que estén continuamente perfeccionándose.
Los aparatos de medida que se utilizan para medir las magnitudes fundamentales son: Longitud → Flexómetro Masa → Balanza
Tiempo → Reloj Temperatura → Termómetro Cantidad de sustancia → Balanza
Intensidad luminosa → Fotocélula Intensidad de corriente → Amperímetro